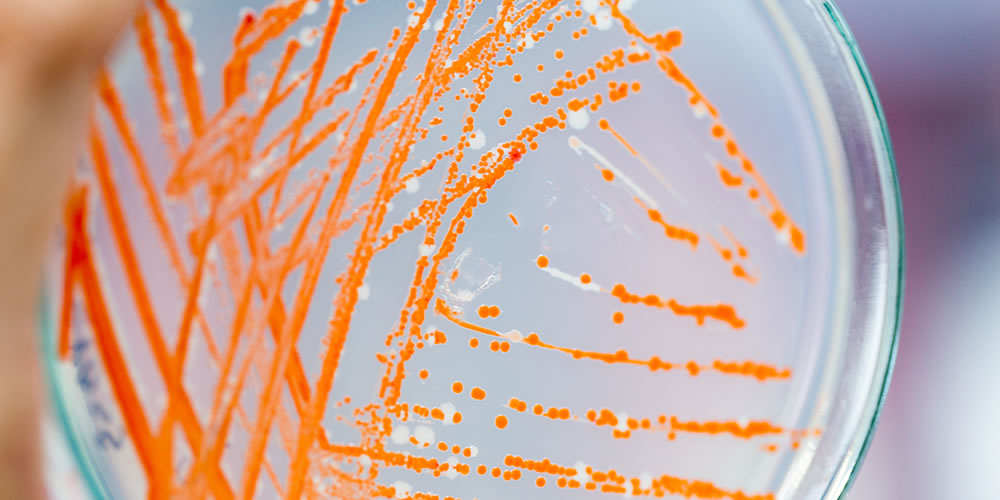
...

Research Technology & Services
About Us
Cleveland Clinic Research’s state-of-the-art cores and facilities offer investigators advanced technologies, equipment and expertise to support laboratory, translational and clinical research.
Our services span multiple departments, centers and locations, and range from basic glassware and information technology resources to personalized support for individual research programs and clinical trials. In addition to supporting our own researchers, some services are also available to investigators outside Cleveland Clinic.

Ohio Cores
Imaging
Medical Device Solutions
Our Medical Device Solutions teams develop innovative prototypes and equipment to enhance research and solve specific clinical needs. Our multidisciplinary staff has extensive experience in medical device design and product development and can support the entire lifecycle of your project, from device ideation to creation.
Center for Immunotherapy & Precision Immuno-Oncology
Case Comprehensive Cancer Center Shared Resources
Cleveland Clinic Research's Shared Laboratory Resources are supported in part by the NIH grant (P30 CA43703) awarded to the Case Comprehensive Cancer Center. Cleveland Clinic Research's Genomics, Imaging and Proteomics & Metabolomics Cores collaborate with Case Shared Resources which may offer technology and services not available at Cleveland Clinic Research.
Partnering to Advance Scientific Discovery
In addition to our work with Cleveland Clinic investigators, we offer scientists and partners across the country access to our technologies and services to advance scientific discoveries. Contact us to discuss opportunities to support your research.
Contact Us